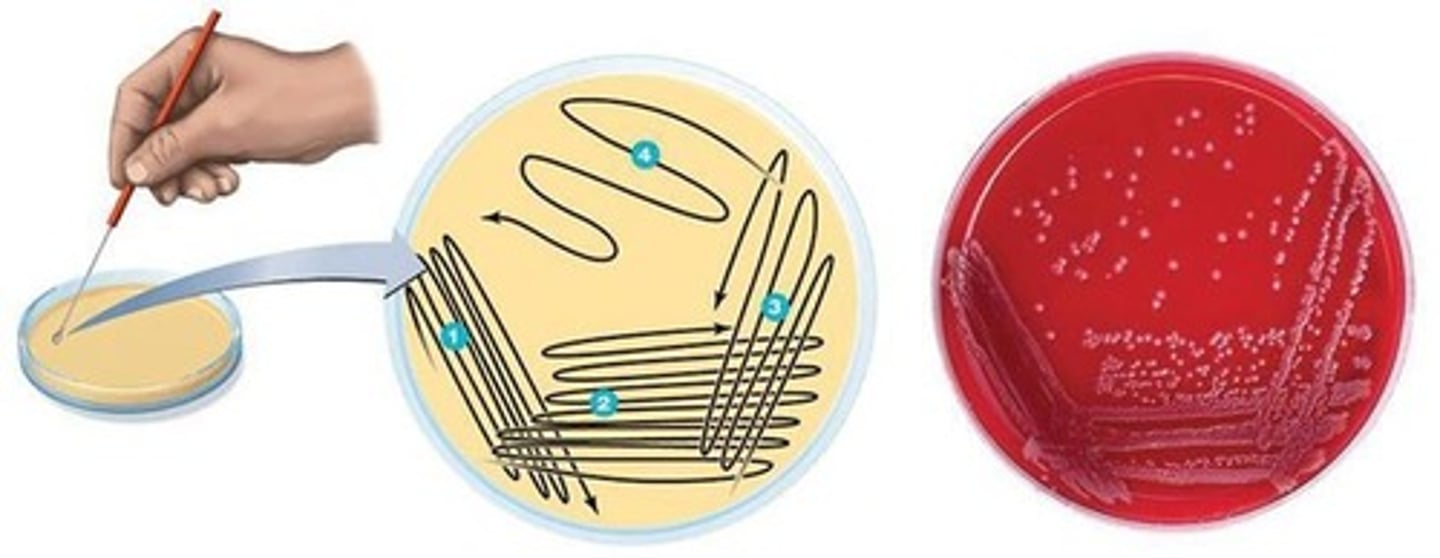
<p>To dilute bacteria cells to obtain individual colonies on an agar plate.</p>
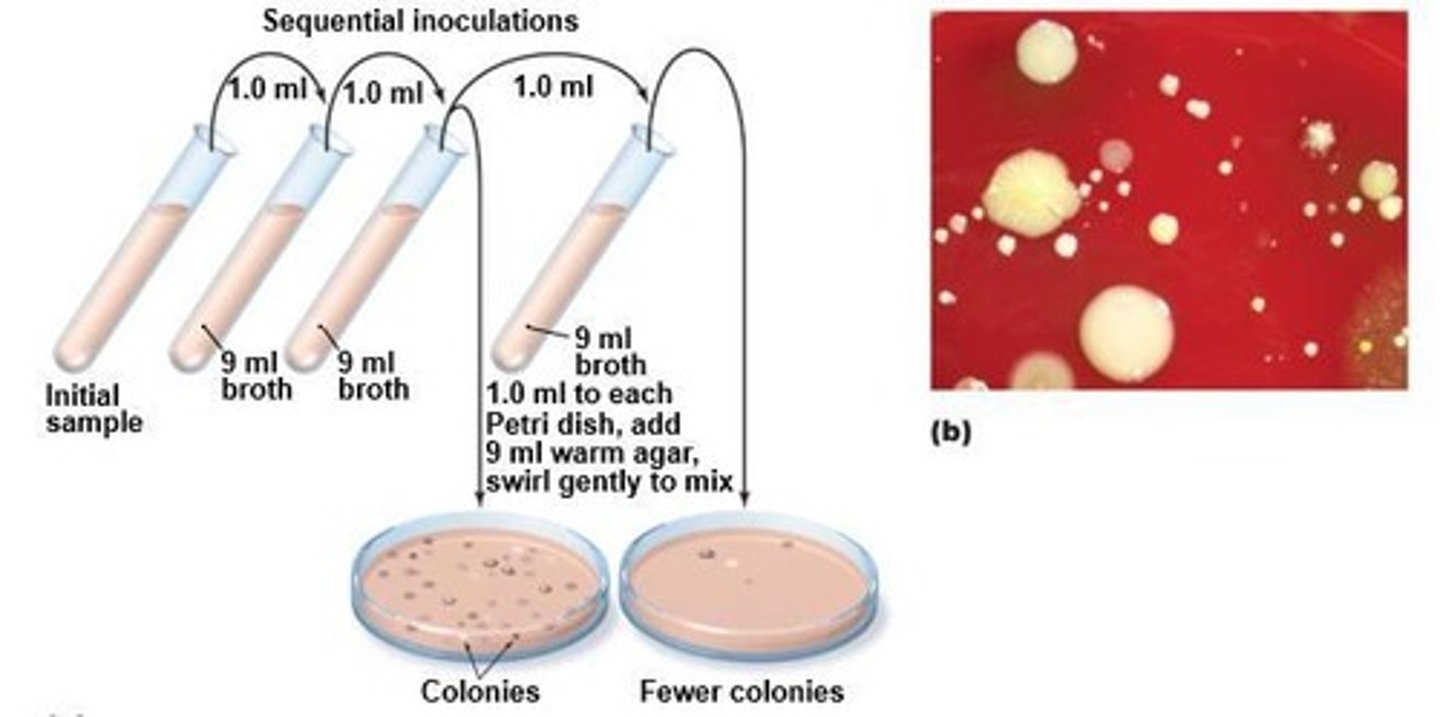
<p>To use a series of dilutions to lower cell concentrations before plating.</p>

1/23
Looks like no tags are added yet.
Name | Mastery | Learn | Test | Matching | Spaced | Call with Kai |
|---|
No analytics yet
Send a link to your students to track their progress
What is the definition of culturing microorganisms as a verb?
The act of growing bacteria.
What does 'culture' refer to as a noun?
The bacteria themselves growing in a nutrient broth or on solid agar.
What is a pure culture?
A culture containing only one species of bacteria.
What is a mixed culture?
A culture containing two or more species of bacteria.
What does inoculate mean in microbiology?
To add bacteria to a nutrient broth or solid agar.
What is the appearance of liquid broth containing growing bacteria?
Cloudy or turbid.
What is agar and where is it derived from?
A polysaccharide that is gelatinous at room temperature, obtained from red seaweed.
What are agar slants used for?
To grow bacteria for storage or to perform biochemical tests.
What is the purpose of agar plates?
To grow bacteria as individual colonies or for antibiotic susceptibility tests.
What is a colony forming unit (CFU)?
A single parent cell that gives rise to a colony on an agar plate.
What is the three-way streak technique used for?
To dilute bacteria cells to obtain individual colonies on an agar plate.
What happens during the first streak in the three-way streak technique?
It has the highest concentration of cells, leading to bacteria growing as a lawn.
What is the purpose of the pour plate technique?
To use a series of dilutions to lower cell concentrations before plating.
What are the six types of culture media?
1) Pure Media, 2) Complex Media, 3) Selective Media, 4) Differential Media, 5) Anaerobic Media, 6) Transport Media.
What is complex media?
Media where nutrients have biological origins and the exact amounts of biochemicals are unknown.
What is selective media?
Media that contains ingredients to inhibit the growth of some species while promoting others.
What is differential media?
Media that contains chemicals causing a change in color or appearance to distinguish between bacteria species.
What is anaerobic media?
Media used for cultures with low oxygen levels or complete absence of oxygen.

What is the purpose of transport media?
To temporarily store microbes during transport from one location to another.
What is generation time in microbiology?
The time required for a bacterial cell to grow and divide.
What is the lag phase in the bacterial growth curve?
A phase characterized by cellular activity but no increase in population size.
What occurs during the log phase of bacterial growth?
Bacteria are dividing and doubling in numbers, with high metabolic activity.

What happens during the stationary phase of bacterial growth?
The number of dividing cells equals the number of dying cells, resulting in no population growth.
What characterizes the death phase in bacterial growth?
The number of dying cells exceeds the number of actively dividing cells, leading to a decrease in population size.